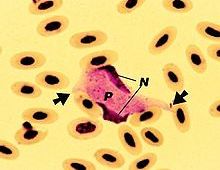

家畜害虫
家畜害虫 ヌカカ(biting midges) ~ 形態・発育および習性・害・防除
ヌカカはきわめて微小な昆虫で、蚊帳の目も通過してしまうほど小さなものが多い。口器は刺咬性で大部分は昆虫の体液を吸いますが、Culicoidesなどは温血動物に対して吸血性をしめします。これらのなかには人や家畜の血液を吸うものがあります。本邦...
 家畜害虫
家畜害虫  胞子虫類
胞子虫類  昆虫類
昆虫類  昆虫類
昆虫類 胞子虫類
胞子虫類  ウマ(馬)の病気
ウマ(馬)の病気  ウマ(馬)の病気
ウマ(馬)の病気  ヤギ(山羊)の病気
ヤギ(山羊)の病気  アヒルの病気
アヒルの病気